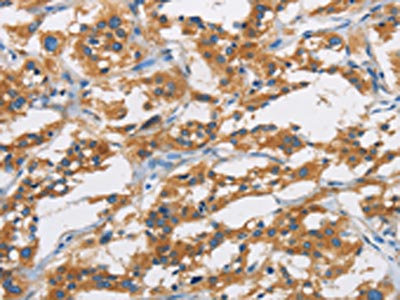

SAR1B Antibody
-
中文名稱:SAR1B兔多克隆抗體
-
貨號:CSB-PA079169
-
規格:¥1100
-
圖片:
-
The image is immunohistochemistry of paraffin-embedded Human thyroid cancer tissue using CSB-PA079169(SAR1B Antibody) at dilution 1/20. (Original magnification: ×200)
-
The image is immunohistochemistry of paraffin-embedded Human liver cancer tissue using CSB-PA079169(SAR1B Antibody) at dilution 1/20. (Original magnification: ×200)
-
-
其他:
產品詳情
-
Uniprot No.:
-
基因名:
-
別名:ANDD antibody; CMRD antibody; GTBPB antibody; GTP binding protein SAR1b antibody; GTP binding protein Sara antibody; GTP-binding protein B antibody; GTP-binding protein SAR1B antibody; SAR1 gene homolog B (S. cerevisiae) antibody; SAR1 homolog B antibody; SAR1a gene homolog 2 antibody; SAR1B antibody; SAR1B_HUMAN antibody; SARA2 antibody; SARB antibody
-
宿主:Rabbit
-
反應種屬:Human,Mouse,Rat
-
免疫原:Fusion protein of Human SAR1B
-
免疫原種屬:Homo sapiens (Human)
-
標記方式:Non-conjugated
-
抗體亞型:IgG
-
純化方式:Antigen affinity purification
-
濃度:It differs from different batches. Please contact us to confirm it.
-
保存緩沖液:-20°C, pH7.4 PBS, 0.05% NaN3, 40% Glycerol
-
產品提供形式:Liquid
-
應用范圍:ELISA,IHC
-
推薦稀釋比:
Application Recommended Dilution ELISA 1:1000-1:2000 IHC 1:25-1:100 -
Protocols:
-
儲存條件:Upon receipt, store at -20°C or -80°C. Avoid repeated freeze.
-
貨期:Basically, we can dispatch the products out in 1-3 working days after receiving your orders. Delivery time maybe differs from different purchasing way or location, please kindly consult your local distributors for specific delivery time.
-
用途:For Research Use Only. Not for use in diagnostic or therapeutic procedures.
相關產品
靶點詳情
-
功能:GTP-binding protein involved in transport from the endoplasmic reticulum to the Golgi apparatus. Activated by the guanine nucleotide exchange factor PREB. Involved in the selection of the protein cargo and the assembly of the COPII coat complex. Synergizes with the cargo receptor SURF4 to mediate the export of lipoproteins from the endoplasmic reticulum, thereby regulating lipoprotein delivery and the maintenance of lipid homeostasis.
-
基因功能參考文獻:
- Study data suggest that SAR1A and SAR1B are the critical regulators of trafficking of Nav1.5. Moreover, SAR1A and SAR1B interact with MOG1, and are required for MOG1-mediated cell surface expression and function of Nav1.5. PMID: 30251687
- Targeted next generation DNA sequencing revealed several rare heterozygous missense variants in both MTTP and APOB genes known or predicted to be deleterious, in addition to a novel heterozygous missense variant in SAR1B, which encodes the gene causing chylomicron retention disease PMID: 29540175
- Report compensatory Sar1a elevation after Sar1b gene deletion in Caco-2/15 cells prevents chylomicron collapse. PMID: 28982670
- SAR1B polymorphisms were associated with Alzheimer's disease (AD) risk; results were not significant after correction for multiple tests. Simultaneous screening using SAR1B rs11948613 and ApoE epsilon4 status offered a better sensitivity for AD screening. PMID: 25703997
- Our data also suggest that Sar1B overexpression contributes to regulation of CHOL transport and metabolism by facilitating rapid uptake and transport of CHOL. PMID: 25826777
- although Sar1A antagonizes the lipoprotein secretion-promoting activity of Sar1B, both isoforms modulate the expression of genes encoding cholesterol biosynthetic enzymes and the synthesis of cholesterol de novo. PMID: 24338480
- the behavior of the human of Sar1A and Sar1B, a key component of the COPII family of vesicle coat proteins, was examined. PMID: 22974979
- Sar1b expression may promote intestinal lipid transport with the involvement of the coat protein complex II network and the processing of SREBP-1c. PMID: 21836065
- Variable phenotypic expression of chylomicron retention disease in a kindred carrying a mutation of the Sara2 gene. PMID: 19846172
- identify eight mutations in SARA2 that are associated with three severe disorders of fat malabsorption PMID: 12692552
- Sara2 is an important gene in processes involving erythroid cell proliferation and differentiation. PMID: 15943909
- Five mutations in the SAR1B gene causing Anderson disease. PMID: 17945526
- muscular as well as cardiac abnormalities that could be related to the reported expression of SARA2 in these tissues PMID: 18786134
顯示更多
收起更多
-
相關疾病:Chylomicron retention disease (CMRD)
-
亞細胞定位:Endoplasmic reticulum membrane; Peripheral membrane protein. Golgi apparatus, Golgi stack membrane; Peripheral membrane protein.
-
蛋白家族:Small GTPase superfamily, SAR1 family
-
組織特異性:Expressed in many tissues including small intestine, liver, muscle and brain.
-
數據庫鏈接:
Most popular with customers
-
-
YWHAB Recombinant Monoclonal Antibody
Applications: ELISA, WB, IHC, IF, FC
Species Reactivity: Human, Mouse, Rat
-
Phospho-YAP1 (S127) Recombinant Monoclonal Antibody
Applications: ELISA, WB, IHC
Species Reactivity: Human
-
-
-
-
-